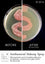
The Pro Hygiene Collection - Antibacterial Makeup Spray 240ml - The Makeup Armoury
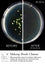
The Pro Hygiene Collection - Makeup Brush Cleaner 240ml - The Makeup Armoury
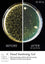
The Pro Hygiene Collection - Hand Sanitizing Gel 240ml (Alcohol Hand Rub) - The Makeup Armoury

The Pro Hygiene Collection
Makeup should be fun, creative and inspiring. But it should also be clean and safe. You shouldn’t have to worry about picking up a nasty bacterial infection when you put on your lipstick or mascara in the morning or when getting ready for a special occasion. But, without sanitized makeup products, brushes, tools and accessories, that’s exactly what could happen, especially when applying to unclean skin, eyes and face.
Luckily, help is at hand. The Pro Hygiene Collection® is the first complete range of specially-designed hygiene and sanitizing products for makeup, tools and accessories and is ideal for both personal use and by makeup and beauty professionals, helping keep you and the industry professionally clean.
4 products
Sort by:
Products per page: